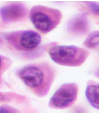

חיבורית Flashcards
(44 cards)
תפקידי רקמת החיבור
תמיכה מבנית - ארכיטקטורה של הגוף
תמיכה מטבולית - העברת חומרים לצריכה
אחסון חומרי הזנה
“שדה הקרב” של תאי השורה הלבנה
תיקון רקמות
פיברובלאסט - תפקיד
מפיק סיבים וחומר ג’ל בין הרקמות (ECM)
אדיפוציט שומן חום - מאפיינים
מפיקה חום מהשומן, מתפתחת באדפטציה לתנאי סביבה קרים
מקור הפוטנציאלי של רקמות החיבור
תאי גזע מסנכימליים - Mesenchymal stem cells. התאים הללו מגיעים לאחר התמיינות מהמסודרם.
תאי מאסט - מאפיינים
דומה לבאזופיל למרות שמגיע ממקור שונה,
מכיל גרנולות עם חומרים שיוצרים תגובה דלקתית (היסטמין, GAG וחומרים שקשורים לתגובה אנאפילקטית)
מציגים IgE נוגדן רגיש במיוחד שגורם ליצירת תגובה אלרגית קשה
מצוי ב:עור, מערכת העיכול, מערכת הנשימה, סביב כלי דם
מאקרופאגים - מאפיינים
מתמיינים ממונוציטים שהפכו פעילים
בעלי יכולת בולענית של חלקיקים ותאים שלמים
יודעים להפריש חומרים שונים לפי צורך
אמורים להיות רק ברקמות החיבור
תאי פלסמה - מאפיינים
מתמיינים מלימפוציטים מסוג B, מרגע ההתמיינות לתא פלסמה לא יחזרו לדם, אחראים על ייצור של נוגדנים בעקבות חדירה של אנטיגן
ECM/חומר חוץ תאי - תפקידים
נותן לתא תנועתיות וכוח התנגדות
מאפשר ומגביל דיפוזיה של חומרים
בעל תפקידים מטבוליים ורגולטוריים
ECM/חומר חוץ תאי - אלמנטים
- ג’ל Ground substance.
- סיבים.
Ground Substance - תפקידים
- מתנגד לכוחות דחיסה.
- אמצעי לשינוע והחלפת חומרים מטבוליים(דיפוזיה).
- מחסום חשוב נגד התפשטות מיקרואורגניזמים.
- מתקשר ומסדיר פעולות חלבונים מופרשים בתאים.
Ground Substance - מבנה
מיוצר ע”י התאים של רקמות החיבור. ברקמות חיבור בסיסיות הוא נוצר בפיברובלאסטים.
מורכב משרשראות פוליסאכרידיות (GAG) שמחוברות לפרוטאוגליקנים.
יוצר ג’ל רווי מים.
גליקוסמינוגליקנים(GAG) - מבנה
שרשראות פוליסאכרידיות שמורכבות מיחידות דיסאכרידיות. לרוב הסוכר יהיה על בסיס גלוקוז או גלקטוז.
אחד משני הסוכרים הוא חומצי (קרבוקסילי) ובשל המטען השלילי החזק של אחד מצידי המולקולה - המים נקשרים היטב ויוצרים ג’ל.
גליקוסמינוגליקנים(GAG) - קבוצות
- היאלרונית - הGAG היחיד שיימצא לבדו ואינו נקשר לחלבון בחומר החוץ תאי.
- כונדרוינטין סולפט ודרמטן סולפט.
- הפרן סולפט.
- קראטן סולפט.
פרוטאוגליקנים - מאפיינים
משתנים בגדלים ובתכונות הכימיות בין פרוטאוגליקנים שונים.
בנוסף ישנם חלבונים שנקראים גליקופרוטאינים שאינם מורכבים מGAG, אלא סוכרים אחרים (בניגוד לפרוטאוגליקנים).
סיבים - תפקיד
להתנגד לכוחות משיכה וגזירה.
קולגן - מאפיינים
הקולגן מיוצר בתוך התאים (לרוב פיברובלאסט), מופרש החוצה ומסתדר כסיב מחוץ לתא.
הקולגן חזק מאוד וקל.
קולגן - מבנה
מורכב משרשרת של חומצות אמינו כאשר כל אחת שלישית היא גליצין (קטנה ונדבקת היטב). השתיים האחרות לרוב פרולין (שמעניק למולקולה את הסיבוב) וליזין.
עם הוספת ההידרוקסיל, השניים עוברים שינוי כימי - הידרוקסילציה והופכים להידרוקסיפרולין והידרוקסיליזין.
קולגן מסוג 1 יהיה מורכב מ-3 שרשראות אלפא הליקס: 2 שרשראות מסוג אלפא 1, ושרשרת אחת מסוג אלפא 2.
סוגי הקולגן
ישנם מעל 25 סוגים, 4 מרכזיים:
קולגן מסוג 1: חזק מאוד. נפוץ בעור, רצועות ועצמות.
קולגן מסוג 2: סיבים יותר דקים ועדינים (בהשוואה לסוג 1). נמצאים בסחוס.
קולגן מסוג 3: שונות, בעלות סידור רשתי. דקות ומעניקות נפח לתאים. נמצאות בשרירים חלקים. הסיבים שיוצר קולגן זה נקראים סיבים רטיקולריים.
זהו הקולגן הראשון שמופרש בריפוי פצעים.
קולגן מסוג 4: אין לו פיברילות, נועד להדביק.
נפוץ בהדבקת העור לרקמת החיבור מתחתיו - באזל למינה.
סיבים רטיקולריים - הרכב ומאפיינים
נוצרים בעיקר מקולגן מסוג 3 יחד עם פרוטאוגליקנים וגליקופרוטאינים.
סיבי קולגן דקים במיוחד שיוצרים רשת מסביב לאיברים שונים כמו כלי דם, עצבים, שרירים, בלוטות לימפה וטחול.
הרשת הרטיקולרית היא גמישה.
אלסטין - מאפיינים
סיבים שנותנים גמישות לרקמה.
חלש יותר מסיבי הקולגן מסוג 1, אך הרבה יותר גמיש מהם.
האלסטין יימצא ברקמות עובריות, ריאות, כלי דם, רשתות האיברים.
אלסטין - הרכב
עשוי ממולקולות של גליקופרוטאינים וביניהן חלבון האלסטין. הם נוצרים בתאים (לרוב פיברובלאסט). כשהתאים פולטים את האלסטין, כיוונו נקבע ע”י גליל שעשוי מגליקופרוטאינים.
סוגי רקמות חיבור לפי צפיפות
הצפיפות נקבעת לפי כמות סיבי הקולגן מסוג 1 ברקמה:
- רקמה לא צפופה/תחוחה - מעט סיבי קולגן והמון תאים.
- רקמה צפופה - המון סיבי קולגן ומעט תאים.
רקמת חיבור לא צפופה/תחוחה - מאפיינים
רקמה גמישה, לא עמידה בפני לחץ, מכילה כלי דם רבים.
מכילה את כל סוגי הסיבים.
יש בה המון חומר ג’ל אמורפי (Ground substance).
הרבה תאים - פיברובלאסטים ומקרופאגים רבים.
בעלת תפקיד חשוב בתגובה הדלקתית ונוכחות של מערכת החיסון.
ממלאת נפח סביב תאי שריר, תומכת רקמת האפיתל ומגנה על כלי דם והלימפה.
רקמת חיבור צפופה - מאפיינים
מאופיינת בסיבים רבים - בעיקר קולגן.
פחות גמישה, הרבה יותר עמידה בלחצים.
יהיו בה פחות תאים.
מחולקת לשני סוגים: מסודרת ולא מסודרת.